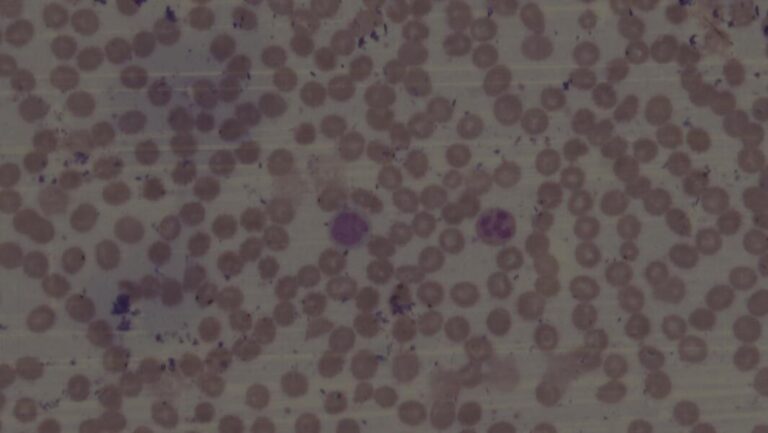
MDS1-Dysplastic cell A hypersegmented neutrophil (left arrow) and macrocytic red blood cells (right arrow) (100x magnification)

Label Your Tubes—Not Your Colleagues!
Volume 39 Number 6 | December 2025 Summary The authors argue that casual stereotypes about medical laboratory professionals—such as calling them introverts or saying they don’t like people—undermine inclusion and belonging. These labels flatten the profession’s diversity and can alienate…